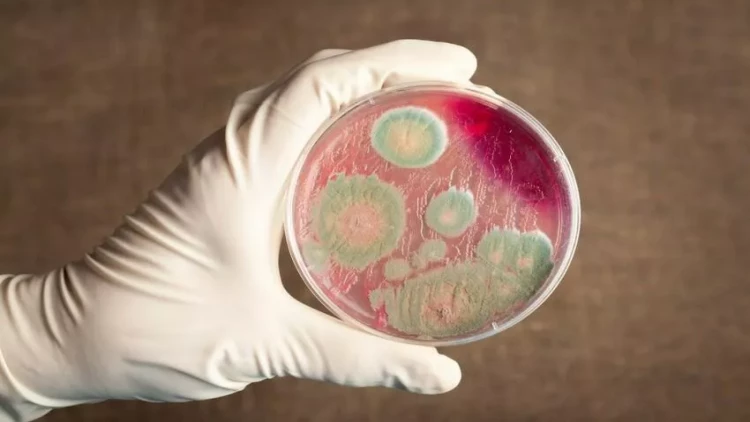
335 nəfərdə qarayara xəstəliyi aşkarlandı - Ölənlər var

335 nəfərdə qarayara xəstəliyi aşkarlandı - Ölənlər var
Zambiyada qarayara xəstəliyinə 330-dan çox yoluxma halı müəyyən edilib, onlardan 4-ü dünyasını dəyişib.
meqale.com report-a istinadən xəbər verir ki, bu barədə ölkənin səhiyyə naziri Silviya Masebo bildirib.
Ölkədə qarayara xəstəliyinə yoluxmaların sayı 335-ə çatıb. On vilayətdən 6-da yoluxma halları aşkarlanıb.
S.Masebo qeyd edib ki, insanlar qarayara aşkarlana heyvanların ətini yeyərək yoluxublar.













